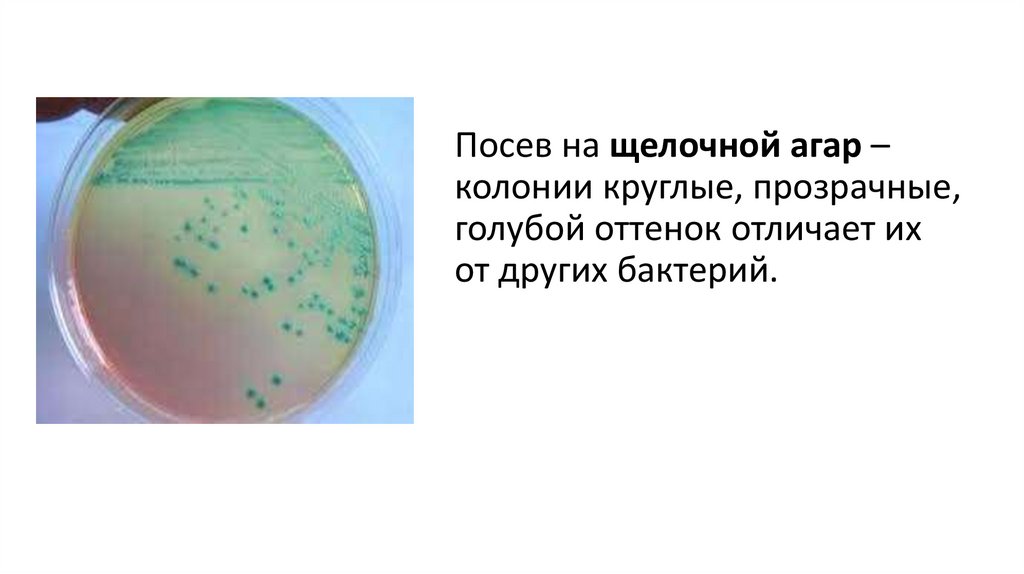
Посев на щелочной агар – колонии круглые, прозрачные, голубой оттенок отличает их от других бактерий.
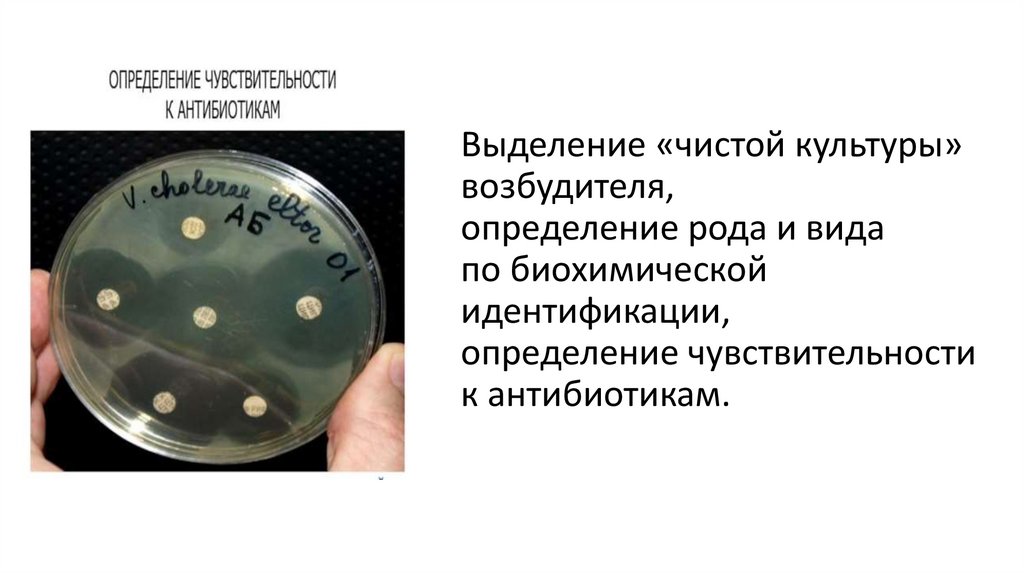
Выделение «чистой культуры» возбудителя, определение рода и вида по биохимической идентификации, определение чувствительности к

Similar presentations:
Холера
1. Преподаватель Карпова В.Н.
2. Материал для исследования
Фекалии,рвотные массы,
кровь,
желчь,
вода.
3.
Материалзабирают
в стерильную
посуду.
Доставляют
с охлаждением.
4.
Холера – это особо опасная инфекция,поэтому биоматериал от больного транспортируют
в тройной упаковке:
• стерильная банка для забора пробы,
• «зип-пакет»,
• контейнер с крышкой.
5. Основной метод исследований – бактериологический.
Оптимальный рост посевов биоматериалапри температуре 370С,
факультативный анаэроб,
но лучше растет при хорошей аэрации,
поэтому на жидких питательных средах
(щелочная 1% пептонная вода)
образует поверхностную пленку,
которая появляется уже через 6 часов.
6. Посев на щелочной агар – колонии круглые, прозрачные, голубой оттенок отличает их от других бактерий.
7. Выделение «чистой культуры» возбудителя, определение рода и вида по биохимической идентификации, определение чувствительности к
антибиотикам.8. Vibrio cholerae
Возбудитель холеры – грамотрицательный вибрион,изогнутый в виде запятой, имеет один полярно
расположенный жгутик, вибрион чрезвычайно подвижен.
9. На основании биохимических и биологических различий холерные вибрионы разделяют на 2 биовара: классический и Эль-Тор.
10.
Холерные вибрионы образуют экзотоксин и эндотоксин.Экзотоксин ответственен
за клинические проявления
заболевания: боли в животе,
рвота, выраженная диарея.
Эндотоксин проявляет
иммуногенные свойства,
вызывает интоксикацию
организма.
11. Преподаватель Карпова В.Н.
Возбудитель холерычувствителен:
• к УФ-лучам,
• высушиванию,
• дезинфектантам,
• кислым значениям рН,
• нагреванию.
12. Источник инфекции – больные холерой и бактерионосители. Основной механизм передачи – фекально-оральный, реже – контактный.
Факторы передачи –вода, пищевые продукты,
объекты окружающей среды.
13. В РФ эндемичными являются Астраханская область и другие районы Волги.
14. Неспецифическая профилактика. Холера относится к антропонозно-сапронозным инфекциям. Для профилактики холеры необходимо
соблюдатьсанитарно-гигиенические требования,
употреблять только обеззараженную
воду и качественные продукты
питания.

medicine
medicine








